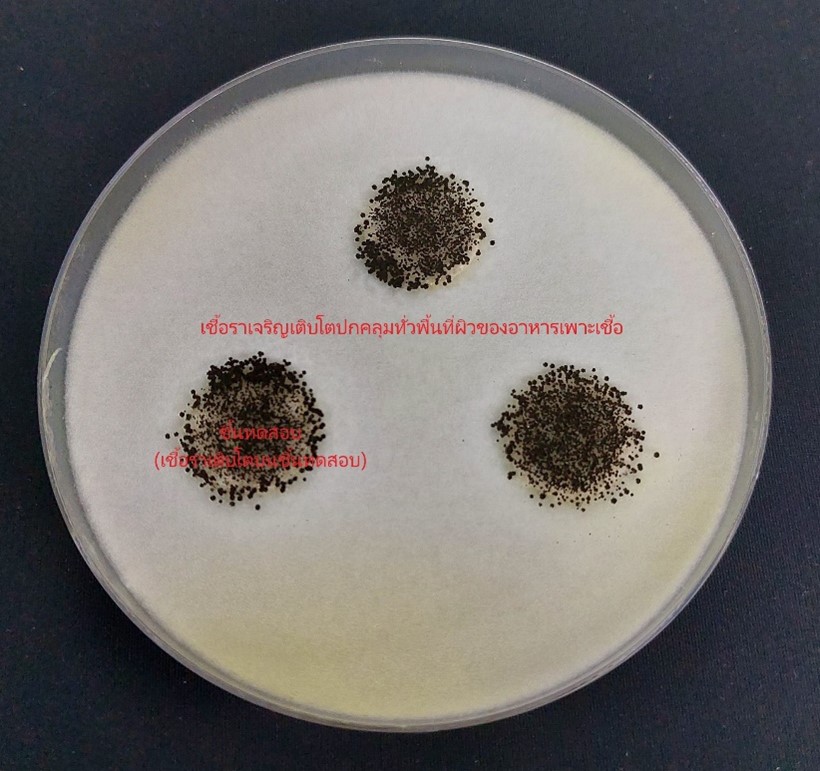

กระดาษสัมผัสอาหาร
กลับหน้าหลัก
23.11.2566 | จำนวนผู้เข้าชม 2223
“อาหาร” คือ 1 ในปัจจัย 4 ที่มีความสำคัญต่อการดำรงชีวิตของมนุษย์ โดยตลอดอายุขัยของมนุษย์คนหนึ่ง มีการบริโภคอาหารทุกๆ วัน วันละหลายมื้อ พร้อมๆ กับมีการใช้ภาชนะต่างๆ ในการบรรจุอาหารเหล่านั้น ไม่ว่าจะเป็น จาน ชาม ถ้วย กล่องฯลฯ ควบคู่กันไปเสมอ
ในอดีตเมื่อใช้งานภาชนะบรรจุอาหารแล้ว นิยมล้างทำความสะอาดและนำกลับมาใช้ใหม่ แต่ด้วยวิถีชีวิตและกิจกรรมประจำวันต่างๆ ที่เปลี่ยนแปลงไป ภาชนะบรรจุอาหารที่ใช้แล้วทิ้ง เริ่มเข้ามามีบทบาททดแทนและได้รับความนิยมใช้งานมากขึ้น เนื่องจากให้ความสะดวก น้ำหนักเบา ราคาไม่แพง ไม่ต้องล้างทำความสะอาด สามารถพกพาไปยังที่ต่างๆ และทิ้งเป็นขยะได้เลย
แต่เนื่องจากภาชนะบรรจุอาหารแบบใช้แล้วทิ้ง มักนิยมผลิตมาจากพลาสติก ซึ่งใช้เวลานานกว่าจะสามารถย่อยสลายได้เองตามธรรมชาติ กลายเป็นขยะตกค้างและก่อให้เกิดปัญหาสิ่งแวดล้อมตามมา
ภาชนะกระดาษบรรจุอาหารจึงเป็นอีกทางเลือกหนึ่งที่ถูกคิดค้นขึ้นมาทดแทนการใช้พลาสติก เนื่องจากสามารถใช้งานได้สะดวกและหลากหลาย สามารถย่อยสลายได้ง่าย มีน้ำหนักเบาและต้นทุนไม่สูงนัก จึงมีแนวโน้มที่จะนิยมนำมาใช้งานเป็นภาชนะบรรจุอาหารมากขึ้นเรื่อยๆ
แต่เป็นที่ทราบกันดีว่าภาชนะกระดาษ มีโครงสร้างที่ไม่แข็งแรงมากนัก เสี่ยงต่อการขาดยุ่ยได้ง่าย อาจทำให้เกิดความกังวลใจต่อการใช้งานทั้งในด้านของความแข็งแรงและความปลอดภัยจากสารเคมีต่างๆ ที่ใช้ในกระบวนการผลิตหรือตกแต่งเพื่อให้ภาชนะกระดาษดังกล่าวมีคุณสมบัติพิเศษ ซึ่งอาจจะมีการปลดปล่อยสารต่างๆ ออกมาปนเปื้อนอาหารที่จะรับประทานได้หรือไม่
เพื่อให้เกิดความมั่นใจว่าภาชนะกระดาษบรรจุหรือสัมผัสอาหาร จะมีความปลอดภัย ไม่มีการถ่ายโอนสารต้านจุลินทรีย์ (antimicrobial constituent) และสารเคมีต่างๆ จากภาชนะกระดาษออกมาปนเปื้อนอาหารที่เราจะรับประทาน โดยมีมาตรฐานผลิตภัณฑ์และมาตรฐานการทดสอบที่เกี่ยวข้องดังต่อไปนี้
1. มาตรฐานผลิตภัณฑ์ มอก. 2948-2562 กระดาษสัมผัสอาหาร (PAPER FOR FOOD CONTACT) (ตารางที่ 1 คุณลักษณะทางเคมี รายการที่ 5 สารต้านจุลินทรีย์ (antimicrobial constituent) ให้ทำการทดสอบตามมาตรฐาน BS EN 1104 โดยเกณฑ์กำหนด จะต้องไม่มีการถ่ายโอนสารต้านจุลินทรีย์)
2. มาตรฐานผลิตภัณฑ์ มอก. 3438-2565 กระดาษสัมผัสอาหาร สำหรับปรุงอาหารด้วยความร้อน (COOKING PAPER) (ตารางที่ 1 ปริมาณสารที่ละลายออกมา (migration) รายการที่ 6สารต้านจุลินทรีย์ (antimicrobial constituent) ให้ทำการทดสอบตามมาตรฐาน BS EN 1104 โดยเกณฑ์กำหนด จะต้องไม่มีการถ่ายโอนสารต้านจุลินทรีย์)
3. มาตรฐานการทดสอบ BS EN 1104: 2018 Paper and board intended to come into contact with food stuffs – Determination of the transfer of antimicrobial constituents
โดยทำการทดสอบกับตัวแทนเชื้อจุลินทรีย์ 2 ประเภท ได้แก่
3.1 แบคทีเรีย
Bacillus subtilis ซึ่งเป็นเชื้อแบคทีเรียชนิดแกรมบวก รูปร่างเป็นท่อน (Rod shape) สามารถสร้างแคปซูล (capsule) และสปอร์ (bacterial spore) ซึ่งเป็นโครงสร้างที่มีความทนทานต่อสภาวะแวดล้อมที่ไม่เหมาะสมต่อการเจริญได้ดี แหล่งอาศัยพบได้ทั่วไปในดิน
มีการถ่ายโอนสารต้านจุลินทรีย์ (ทดสอบกับเชื้อแบคทีเรีย Bacillus subtilis)
(สารต้านจุลินทรีย์จากชิ้นทดสอบแพร่ออกมาฆ่าเชื้อแบคทีเรียที่อยู่โดยรอบ)
ไม่มีการถ่ายโอนสารต้านจุลินทรีย์ (ทดสอบกับเชื้อแบคทีเรีย Bacillus subtilis)
(สารต้านจุลินทรีย์จากชิ้นทดสอบไม่แพร่ออกมา ทำให้แบคทีเรียที่อยู่โดยรอบยังคงเจริญเติบโตได้)
3.2เชื้อรา
Aspergillus nigerเป็นเชื้อราที่พบได้ทั้งในรูปของการสืบพันธุ์แบบไม่อาศัยเพศและแบบอาศัยเพศ การสืบพันธุ์แบบไม่อาศัยเพศจะสร้างสปอร์แบบไม่อาศัยเพศ เรียกว่า conidia พบทั่วไปในสิ่งแวดล้อม เป็นสาเหตุที่ทำให้อาหารเน่าเสีย (microbial spoilage)
มีการถ่ายโอนสารต้านจุลินทรีย์ (ทดสอบกับเชื้อรา Aspergillus niger)
(สารต้านจุลินทรีย์จากชิ้นทดสอบแพร่ออกมาฆ่าเชื้อราที่อยู่โดยรอบ)
ไม่มีการถ่ายโอนสารต้านจุลินทรีย์ (ทดสอบกับเชื้อรา Aspergillus niger)
(สารต้านจุลินทรีย์จากชิ้นทดสอบไม่แพร่ออกมา ทำให้เชื้อราที่อยู่โดยรอบยังคงเจริญเติบโตได้)
สิ่งทอ,สิ่งทอ